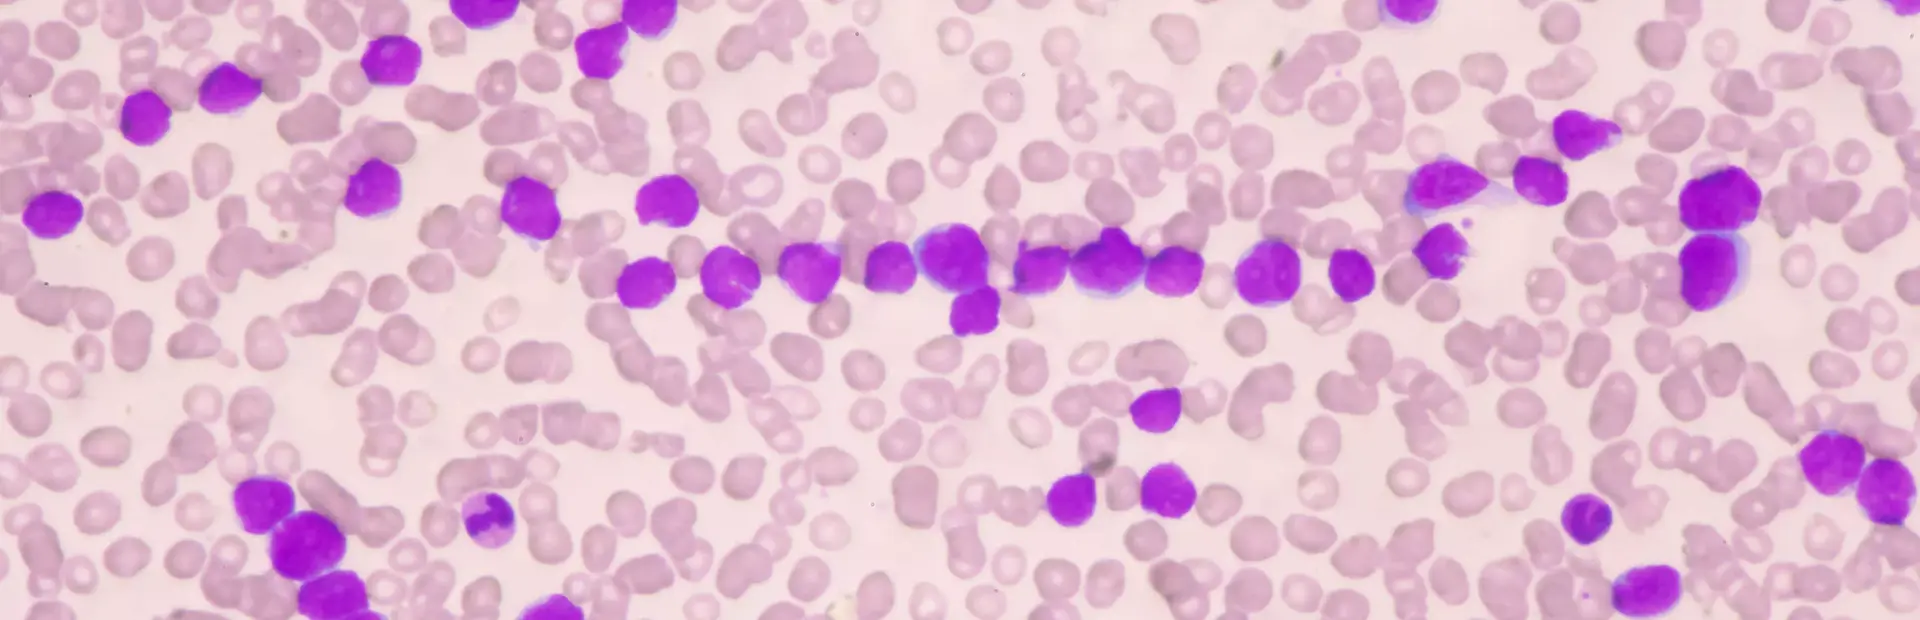

Si te han diagnosticado Leucemia Mieloide Crónica (LMC) o conoces a alguien que la padezca, seguramente sabrás que la fatiga1 es uno de los síntomas más comunes durante el tratamiento. La sensación de cansancio constante, además de otros efectos de la medicación, puede tener un gran impacto en las actividades del día a día; como lo es el trabajo.
La LMC es una enfermedad hematológica que ocurre debido a la mutación del gen BCR-ABL (2). Esta anomalía genética provoca que la médula ósea no funcione correctamente y, por ello, produzca células sanguíneas inmaduras1 (o leucémicas) que no llegan a convertirse ni en plaquetas, ni en glóbulos rojos ni en glóbulos blancos.
La LMC se caracteriza porque tiene un avance más lento que otro tipo de leucemias y, por lo general, suele detectarse en una fase temprana poco agresiva. Esta característica permite tratar la enfermedad de forma temprana y contribuir así a detener el avance de la enfermedad. Este proceso no es fácil debido al impacto que tiene en el entorno familiar, social y laboral y los cambios que puede exigir en el estilo de vida de la persona1.
Pese al diagnóstico, ten en cuenta que mayoritariamente es posible realizar una vida normal durante el tratamiento gracias al acompañamiento médico y con el apoyo de tu círculo social, familiar y laboral3. ¡Tener LMC no necesariamente implica que tengas que dejar tu trabajo! Tal como comentábamos al principio, uno de los síntomas que más puede afectar a tu vida laboral puede ser la fatiga, así como la aparición de otros efectos adversos al tratamiento. Por ello, te damos unos consejos para aprender a gestionar la LMC en el trabajo:
- En la medida que consideres, compartir con tus compañeros de trabajo tu diagnóstico puede ayudarte a encontrar apoyo y acompañamiento en el entono laboral durante el proceso de la enfermedad.
- Adapta tu rutina laboral según tus energías: planifica en la medida de lo posible el volumen de trabajo para que en los días en los que te sientas más fatigado, puedas gestionarlo.
- Adapta tus horarios y desplazamientos en función de tus necesidades de salud.
- Anota cómo te sientes y puntúa tu fatiga. Analiza qué días te afecta más para reajustar tu día a día.
- Habla con tu médico de cualquier duda que te pueda surgir sobre cómo vivir con LMC.
Lo más importante si padeces LMC es aprender a convivir con ella, pues es una enfermedad crónica. Fortalecer tus redes de apoyo y compartir tu caso con las personas más cercanas a ti seguro que te ayudará a disminuir los posibles efectos psicológicos que una enfermedad de este tipo genera.
Así mismo, recuerda que siempre podrás buscar apoyo psicológico en tu centro de salud o en las asociaciones de pacientes, quienes podrán darte toda la información y acompañamiento que necesites.